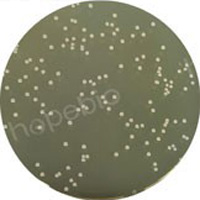

海博微信公众号
海博微信公众号
 海博天猫旗舰店
海博天猫旗舰店


 海博微信公众号
海博微信公众号
 海博天猫旗舰店
海博天猫旗舰店




微生物是地球上分布最广、种类最多的生命形式,在自然界物质循环中扮演关键角色。长期以来,人们对微生物的认知多停留在“致病”层面,却忽视了大量与人类共生、服务于饮食生活的可食用微生物。从传统发酵食品到现代益生菌制剂,从餐桌常见的食用菌到工业发酵产物,可食用微生物早已深度融入人类饮食体系,不仅丰富了食物种类与风味,更成为维护人体健康的重要资源。
一、可食用微生物的定义与分类
可食用微生物是指可直接食用、用于食品发酵加工或产生可食用代谢产物,且对人体安全无害的微生物类群,主要包括细菌、真菌(酵母菌、霉菌、大型真菌)等。与病原微生物不同,这类微生物经过长期食用验证,不产生毒素,部分还能为人体提供营养或生理活性物质。按照应用方式,可将其分为三大类。
1、食用益生菌
益生菌是定植于人体肠道、生殖系统内,能改善宿主微生态平衡的活性微生物,可直接食用。常见种类包括乳酸菌属、双歧杆菌属、肠球菌属及部分芽孢杆菌等。这类微生物多以酸奶、益生菌饮料、片剂等形式存在,是现代健康食品的核心成分。
(1)乳酸菌属,这是一类能发酵糖类主要产生乳酸的细菌总称,是益生菌中最常见的种类。常见的益生菌菌种主要有嗜酸乳杆菌、植物乳杆菌、保加利亚乳杆菌等,培养常用的培养基主要为MRS琼脂培养基。

图1 德氏乳杆菌保加利亚亚种和嗜热链球菌在MRS培养基上的生长状态
(2)双歧杆菌属,这是人体肠道内最重要的生理性有益菌之一。它们能抑制有害菌生长,促进营养吸收,并增强肠道屏障功能。常见的益生菌菌种主要有婴儿双歧杆菌、长双歧杆菌等,培养常用的培养基主要有BBL琼脂培养基、BBL液体培养基、BL琼脂培养基等。

图2 双歧杆菌在BBL琼脂培养基上的生长状态
(3)肠球菌属,常见的益生菌菌种主要为粪肠球菌,可以促进肠道蠕动,改善便秘。培养常用的培养基主要有胰蛋白胨大豆琼脂培养基等。
图3 粪肠球菌在胰蛋白胨大豆琼脂培养基上的生长状态
(4)部分芽孢杆菌,常见的益生菌菌种主要为枯草芽孢杆菌,耐酸耐胆盐,可在肠道存活并抑制病原菌。培养常用的培养基主要有营养琼脂培养基等。

图4 枯草芽孢杆菌在营养琼脂培养基上的生长状态
2、食品发酵用微生物
这类微生物不直接作为单体食用,而是通过发酵作用将原料转化为风味独特、易于吸收的食品,是传统饮食文化的核心载体。主要包括:酵母菌(酿酒酵母、面包酵母),用于酒类、面包、馒头发酵;霉菌(米曲霉、毛霉、根霉),用于酱油、腐乳、豆豉、甜面酱酿造;乳酸菌复合菌群,用于泡菜、酸菜、奶酪发酵。

图5 酵母菌在PDA培养基上的生长状态
3、大型食用真菌
大型真菌俗称食用菌,属于真菌界,是肉眼可见、可直接烹饪食用的微生物,也是最易被大众接受的可食用微生物。常见种类有香菇、平菇、金针菇、木耳、银耳、杏鲍菇、猴头菇、灵芝等,全球可食用食用菌超过2000种,中国是世界上食用菌资源最丰富、食用历史最悠久的国家之一。

图6 常见的大型食用真菌(图源来自网络)
二、可食用微生物在传统食品中的应用
人类利用可食用微生物的历史长达数千年,在没有现代微生物技术的时代,通过自然发酵经验形成了独特的饮食文化,其本质是对微生物的无意识利用。
1、发酵乳制品是益生菌应用最广泛的领域。早在数千年前,中东地区就出现了自然发酵的酸奶,中国少数民族地区也有奶酒、奶豆腐等传统食品。保加利亚乳杆菌与嗜热链球菌协同发酵牛奶,将乳糖转化为乳酸,使牛奶凝固形成酸奶,不仅延长了保质期,还让营养更易吸收。乳酸菌发酵产生的乳酸、醋酸等有机酸,能抑制有害菌生长,同时赋予产品清爽的酸味。
2、酿造类食品离不开霉菌与酵母菌的共同作用。以酱油酿造为例,米曲霉是核心菌种,它能产生蛋白酶、淀粉酶,将大豆、小麦中的蛋白质、淀粉分解为氨基酸、葡萄糖等小分子物质,为后续酵母菌发酵提供底物。酵母菌则利用糖类进行酒精发酵,进一步转化为有机酸、酯类物质,形成酱油独特的酱香与鲜味。腐乳制作则依赖毛霉,毛霉生长产生的蛋白酶将豆腐中的蛋白质分解,使豆腐质地变软、风味醇厚,同时形成独特的腐乳香。
3、食用菌更是传统饮食的重要组成部分。中国早在《神农本草经》中就有灵芝、茯苓的记载,将其视为药食同源食材。香菇、木耳等作为家常菜,不仅口感鲜美,还能为素食提供优质蛋白,是中式烹饪中不可或缺的食材。
三、可食用微生物的营养与健康价值
可食用微生物不仅是食物加工的“工具”,更是营养与健康的“宝库”,其价值体现在营养提升、肠道调节、免疫增强等多个方面。
益生菌是肠道健康的守护者。益生菌可通过产酸降低肠道pH值,抑制致病菌定植;促进肠道黏膜修复,增强肠道屏障功能;调节肠道菌群平衡,改善便秘、腹泻等肠道问题。
发酵微生物能提升食物营养价值。微生物发酵可将大分子营养物质分解为小分子,如蛋白质分解为氨基酸、淀粉分解为单糖,更易被人体消化吸收。发酵过程还能产生维生素B12、叶酸等人体自身无法合成的营养素,同时消除原料中的抗营养因子,提高食物安全性与利用率。
食用菌是优质的营养库。其蛋白质含量远高于普通蔬菜,氨基酸种类齐全,含有人体必需的八种氨基酸,被称为“植物肉”。同时,食用菌富含膳食纤维、维生素B族、钾、磷、铁等矿物质,以及香菇多糖、银耳多糖、三萜类化合物等生物活性物质。这些活性成分具有抗氧化、增强免疫力、调节血脂等作用,符合现代健康饮食理念。
四、产品展示
我公司有多种可培养可食用微生物的产品,客户可根据实际情况和用途进行选用。
表1 产品信息
|
产品货号 |
产品名称 |
用途 |
|
HB0384 |
用于食品中乳酸菌的分离培养或计数 |
|
|
HB0396 |
用于双歧杆菌的分离培养 |
|
|
HB8777 |
用于双歧杆菌增菌培养 |
|
|
HB0177 |
一种通用的营养培养基,用于各种微生物的培养 |
|
|
HB0109 |
用于一般细菌培养、转种、复壮和增菌等 |
|
|
HB0233 |
用于霉菌和酵母菌计数 |
注:本文属海博生物原创,未经允许不得转载。
上一篇:酚红的特性及在培养基中的作用
下一篇:去皮切块的甘蔗能吃吗
| 相关文章: |



